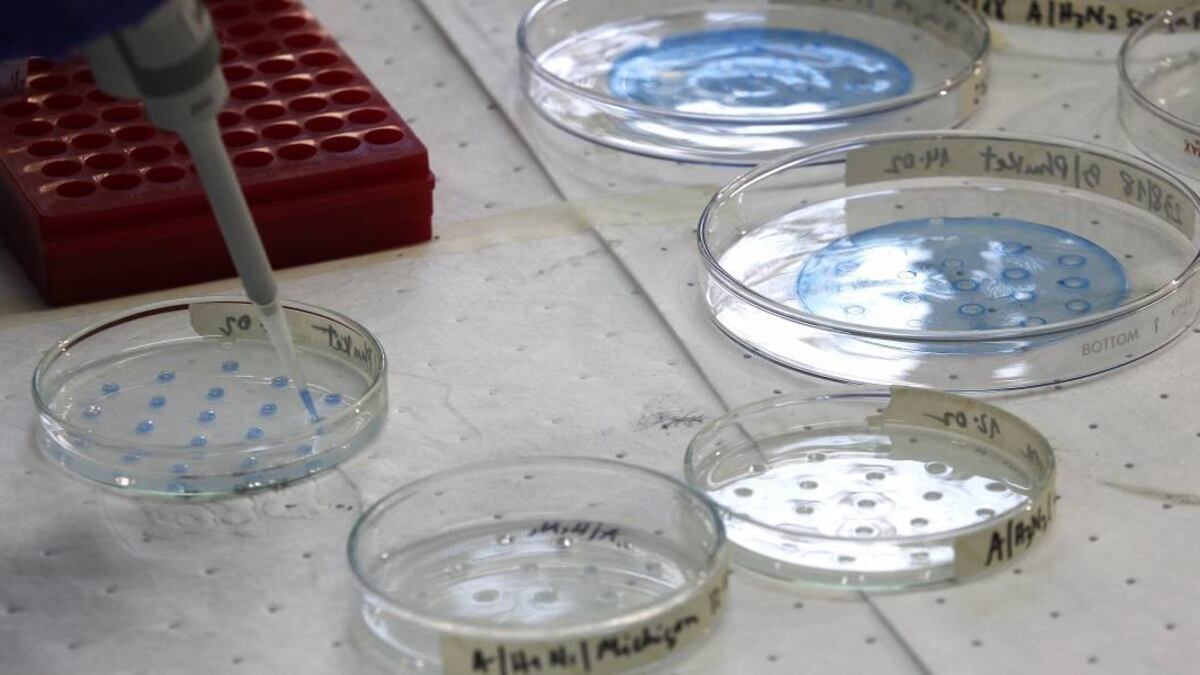

Una nueva variante del coronavirus está causando un repunte de la enfermedad en Sudáfrica incluyendo casos, hospitalizaciones y decesos, informaron las autoridades locales.
La nueva variante, llamada 501.V2, está presenta en las más recientes infecciones en Sudáfrica, indicaron autoridades de salud y expertos científicos del país.
La nueva variante, distinta a la que ha aparecido en Gran Bretaña, al parecer es aún más contagiosa que la versión original. Científicos sudafricanos están averiguando si la vacuna contra covid-19 también proteger contra la nueva versión.
El profesor Salim Abdool Karim, presidente de la comisión ministerial que asesora al gobierno, declaró en una sesión informativa con periodistas que, según datos preliminares, el nuevo tipo de virus es el más dominante en la nueva ola de contagios que padece Sudáfrica.
Actualmente Sudáfrica tiene más de 8.500 personas hospitalizadas con covid-19, comparado con el récord anterior de 8.300 registrado en agosto.